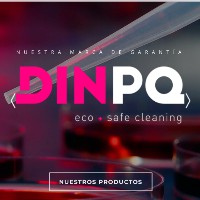
José Aviles

Company Details
- Employees
- 18
- Founded
- 1990
- Address
- Monserrat
- Industry
- Chemical Manufacturing
- NAICS
-
Chemical ManufacturingSoap, Cleaning Compound, and Toilet Preparation ManufacturingOther Chemical Product and Preparation ManufacturingPrinting Ink ManufacturingExplosives ManufacturingAll Other Chemical Product and Preparation ManufacturingCustom Compounding of Purchased ResinsPhotographic Film, Paper, Plate, and Chemical ManufacturingAll Other Miscellaneous Chemical Product and Preparation Manufacturing
- Website
- http://www.racrisa.com
- HQ
- MONSERRAT